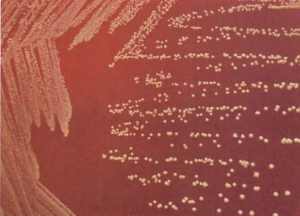
图 8星形诺卡菌在血琼脂平板上的菌落特征(48h)
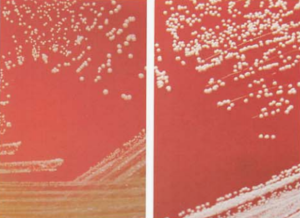
图 9星形诺卡菌在血琼脂平板上的咬琼脂现象(48h,左图黄色,右图白色)
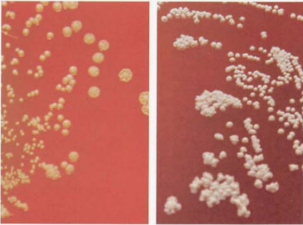
图 10星形诺卡菌在血琼脂平板上的菌落特征(72h,左图黄色,右图白色)
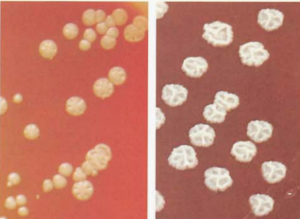
图 11星形诺卡菌在血琼脂平板上的菌落特征(96h.左图黄色,右图白色)
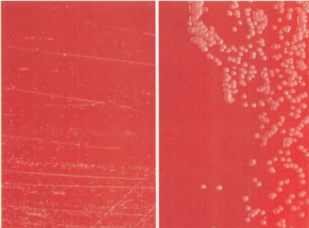
图 12 星形诺卡菌与链霉菌菌落大小的鉴别左图为星形诺卡菌;右图为链霉菌
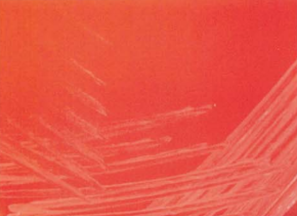
图 15巴西诺卡菌在血琼脂平板上的菌落特征(18~24h)
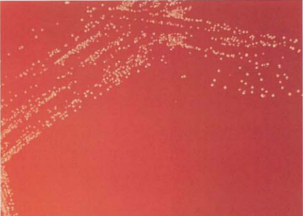
图 16巴西诺卡菌在血琼脂平板上的菌落特征(48h)
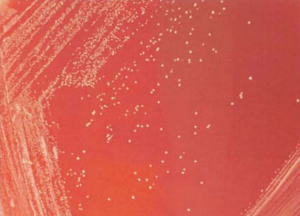
图 20豚鼠耳炎诺卡菌在血琼脂平板上的菌落特征(48h)
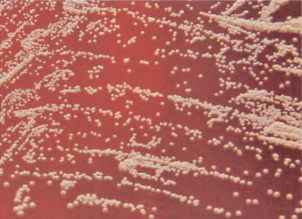
图 21豚鼠耳炎诺卡菌在血琼脂平板上的菌落特征(72h)
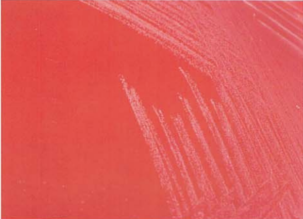
图 24 皮氏诺卡菌在血琼脂平板上的菌落特征(18~24h)
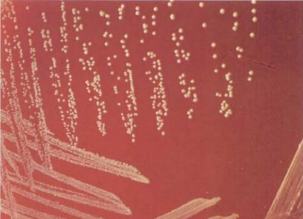
图 25 皮氏诺卡菌在血琼脂平板上的菌落特征(48h)

诺卡菌属的形态特性与生理生化反应
来源:武汉市灰藻生物科技有限公司 浏览量:114 发布时间:2026-03-28 20:42:41
诺卡菌属与星形诺卡菌(N. asteroides)
诺卡菌属包括脓肿诺卡菌(N. abscessus)、巴西诺卡菌(N. brasiliensis)、皮氏诺卡菌(N. farcinica)、星形诺卡菌(N. asteroides)、
豚鼠耳炎诺卡菌(N. otitidiscaviarum)、假巴西诺卡菌(N. pseudobrasiliensis)、老兵诺卡菌(N. veterana)、圣乔治诺卡菌(N. cyriacigeorgica)和华莱士诺卡菌(N. wallacei)等。
一、星形诺卡菌(N. asteroides)
(一)星形诺卡菌形态与染色
革兰阳性,菌体为丝状,称为菌丝或菌丝体。培养早期可见丰富的菌丝体,常有次级分枝,菌丝呈90°分枝角(图 1);
随着培养时间延长(48h、96h、120h)(图 2~图 4),菌体裂解为球形或杆状。

图 1星形诺卡菌纯培养的镜下形态(革兰染色,18~24h)

图 2 星形诺卡菌纯培养的镜下形态(革兰染色,48h)

图 3 星形诺卡菌纯培养的镜下形态(革兰染色,96h)

图 4星形诺卡菌纯培养的镜下形态(革兰染色,120h)
在脓液、痰和脑脊液等临床标本中,为纤细的分枝状菌丝。抗酸染色弱阳性。血培养阳性培养物直接涂片见到纤细的分枝状菌丝(图 5)。

图 5 血培养阳性培养物直接涂片(革兰染色)
(二)星形诺卡菌培养特性
诺卡菌为严格需氧菌。在沙氏培养基(SDA)或营养琼脂培养基上,22 ℃或35℃均可缓慢生长,需2~3日可见菌落(图 6)。
在血琼脂平板上培养18~24h,菌落针尖大小,不易观察到(图 7),48 h后逐渐增大,见“咬琼脂”现象,菌落表面有皱褶(图 8~图 11)。

图 6 星形诺卡菌在SDA上的菌落特征(5~7日)

图 7 星形诺卡菌在血琼脂平板上的菌落特征(24h)
图 8星形诺卡菌在血琼脂平板上的菌落特征(48h)
图 9星形诺卡菌在血琼脂平板上的咬琼脂现象(48h,左图黄色,右图白色)
图 10星形诺卡菌在血琼脂平板上的菌落特征(72h,左图黄色,右图白色)
图 11星形诺卡菌在血琼脂平板上的菌落特征(96h.左图黄色,右图白色)
在不同培养基上或不同的培养时间菌落形态差异很大,可出现光滑到颗粒状、不规则、表面皱褶或堆积的菌落。
几乎都能形成气生菌丝,使菌落表面出现粉状或天鹅绒样气生菌丝体,菌落有泥土气味。可产生不同的色素,如橙红、粉红、黄色、黄绿、紫以及其他颜色。
多数星形诺卡菌的菌落为黄色或深橙色,也可呈乳白色。诺卡菌在液体培养基中生长形成菌膜,浮于液面,液体澄清。
(三)星形诺卡菌生化反应
触酶试验阳性,主要生化反应见表 1。
| 试验 | 结果 | 试验 | 结果 |
|---|---|---|---|
| 45 ℃生长 | – | 次黄嘌呤 | – |
| 芳基硫酸酯酶 | + | 酪氨酸 | – |
| 硝酸盐 | + | 黄嘌呤 | – |
| 脲酶 | + | 乙酰胺 | – |
| 腺嘌呤 | – | 枸橼酸盐 | – |
| 酪蛋白 | – | 鼠李糖 | – |
| 七叶苷 | – | 山梨醇 | – |
注:+,90%以上菌株阳性;–,90%以上菌株阴性
(四)星形诺卡菌鉴别要点
1. 本菌特征:革兰阳性,菌体为丝状,菌丝呈90°分枝角,有诊断意义。生长缓慢,菌落较小,多数有泥土气味。革兰染色阳性或不定,弱抗酸染色阳性(脱色剂为1%硫酸水溶液)。
2. 与快速生长分枝杆菌的鉴别:星形诺卡菌革兰染色性强,抗酸染色性弱,盐酸乙醇易脱色,菌体呈丝状;快速分枝杆菌抗酸性强,不易脱色,革兰染色弱。
3. 与红球菌属的鉴别:两者均可呈现弱抗酸,星形诺卡菌对青霉素耐药,有气生菌丝,耐受溶菌酶,而红球菌属则相反。
4. 与棒杆菌属的鉴别:星形诺卡菌菌体呈丝状,有气生菌丝;而棒杆菌属菌体一端或两端膨大呈棒状,不形成菌丝。延长培养时间,观察有无菌丝体出现,便可区分。
5. 与链霉菌菌落大小的鉴别:诺卡菌生长缓慢,培养48 h后菌落针尖状大小,而链霉菌菌落较大(图 12)。
图 12 星形诺卡菌与链霉菌菌落大小的鉴别左图为星形诺卡菌;右图为链霉菌
6. 与其他诺卡菌的鉴别:见表 2。
| 菌种 | 45 ℃生长 | 芳基硫酸酯酶 | 硝酸盐 | 脲酶 | 腺嘌呤 | 酪蛋白 | 七叶苷 | 次黄嘌呤 | 酪氨酸 | 黄嘌呤 | 乙酰胺 | 枸橼酸盐 | 鼠李糖 | 山梨醇 |
|---|---|---|---|---|---|---|---|---|---|---|---|---|---|---|
| 星形诺卡菌 | – | + | + | + | – | – | – | – | – | – | – | – | – | – |
| 脓肿诺卡菌 | – | – | + | + | – | – | – | – | – | – | – | + | – | – |
| 巴西诺卡菌 | – | – | + | + | – | + | + | + | + | – | – | + | – | – |
| 皮氏诺卡菌 | – | – | – | + | – | – | – | – | + | – | + | – | + | – |
| 豚鼠耳炎诺卡菌 | V | ND | – | + | – | – | + | + | – | – | – | – | – | – |
| 假巴西诺卡菌 | – | – | – | + | + | + | + | – | + | – | ND | + | – | – |
| 华莱士诺卡菌 | + | – | ND | + | – | – | + | + | – | – | – | + | – | – |
| 圣乔治诺卡菌 | – | ND | + | – | – | – | – | – | – | – | + | – | – | – |
注:+,90%以上菌株阳性;–,90%以上菌株阴性;V,11%~89%菌株阳性;ND,无资料
7. 与其他相关菌属的鉴别:见表 3。
| 特性 | 诺卡菌属 | 冢村菌属 | 红球菌属 | 戈登菌属 | 嗜皮菌属 | 链霉菌属 | 拟诺卡菌属 | 假诺卡菌属 | 糖单胞菌属 | 糖多胞菌属 | 迪茨菌属 | 高温放线菌属 | 马杜拉放线菌属 |
|---|---|---|---|---|---|---|---|---|---|---|---|---|---|
| 动力 | – | ND | – | – | + | – | – | – | – | – | – | ND | – |
| 气生菌丝 | + | – | – | – | + | + | + | V | + | + | – | V | V |
| 分枝菌酸 | + | + | + | + | – | – | – | – | – | – | + | ND | – |
| 抗酸性 | 弱+ | 弱+ | 弱+ | 弱+ | – | – | – | – | – | – | – | ND | – |
| 溶菌酶 | + | + | – | V | ND | – | ND | ND | – | – | – | ND | + |
注:+,90%以上菌株阳性;–,90%以上菌株阴性;V,11%~89%菌株阳性;弱+,弱阳性;ND,无资料
8. 根据药敏结果、菌落形态及生化反应等结果综合鉴定诺卡菌:见表 4~表 6。
| 菌名 | 庆大霉素 | 妥布霉素 | 阿米卡星 | 红霉素 | 结果 |
|---|---|---|---|---|---|
| 新诺卡菌 | S | S | S | S | SSSS |
| 新诺卡菌 | S | R | S | S | SRSS |
| 新诺卡菌、皮诺卡菌 | R | R | S | S | RRSS |
| 短链诺卡菌 | R | S | S | R | RSSR |
| 皮诺卡菌、星形诺卡菌Ⅳ | R | R | S | R | RRSR |
| 巴西诺卡菌、假巴西诺卡菌、星形诺卡菌Ⅰ/Ⅵ、豚鼠耳炎诺卡菌 | S | S | S | R | SSSR |
| 豚鼠耳炎诺卡菌、星形诺卡菌Ⅰ/Ⅳ | S | R | S | R | SRSR |
| 德兰士瓦诺卡菌、星形诺卡菌Ⅳ | R | R | R | R | RRRR |
| 德兰士瓦诺卡菌、星形诺卡菌Ⅳ | S | R | R | R | SRRR |
注:S,敏感;R,耐药
表 5依据诺卡菌的药敏试验结果、关键生化反应判断细菌种类

注:acet,乙酰胺利用:ado,侧金盏花醇:ino.肌醇:cl,枸橼酸盐利用试验
| 菌种 | 硫酸酯酶 (7日) | 乙酰胺 (5日) | 明胶液化 (7日) | 35 ℃/45 ℃ (3日) | 生长变浊 (7日) | API20C同化试验(4~7日) | ||||||
|---|---|---|---|---|---|---|---|---|---|---|---|---|
| glu | gly | gal | nag | lno | ado | tre | ||||||
| 新诺卡菌 | +(89) | — | — | —(95) | — | + | — | — | — | — | — | — |
| 星形诺卡菌Ⅰ | — | —(88) | — | — | — | + | + | — | +(63) | — | — | — |
| 星形诺卡菌Ⅵ | — | —(60) | — | +(60) | — | + | +(90) | — | — | — | — | —(80) |
| 星形诺卡菌Ⅳ | — | — | — | — | — | + | + | + | — | — | — | + |
| 皮诺卡菌 | — | + | — | + | +(94) | + | + | +(63) | — | — | — | —(94) |
| 豚鼠耳炎诺卡菌 | — | — | — | —(88) | — | + | + | —(75) | + | + | — | +(50) |
| 巴西诺卡菌 | — | — | +(83) | — | — | + | + | + | + | + | — | + |
| 假巴西诺卡菌 | — | — | + | — | — | + | + | + | + | + | — | + |
| 德兰士瓦诺卡菌 | — | — | — | — | — | + | + | + | + | — | + | — |
| 短链诺卡菌 | — | — | — | — | — | — | — | — | — | — | — | + |
注: glu,葡萄糖;gly,甘油;gal,半乳糖;nag,N-乙酰-D-葡萄糖胺;ino,肌醇;ado,侧金盏花醇;tre,菌藻糖。()内数字为阳性或阴性百分比%; 35 ℃/45 ℃, 35 ℃/45 ℃生长;+,阳性;—,阴性
(五)星形诺卡菌药敏试验的药物种类选择
K-B法不适用于诺卡菌的药敏试验,CLSI推荐稀释法测定诺卡菌的MIC,折点判断标准见CLSI M24-A2。
新诺卡菌及其他需氧放线菌微量肉汤稀释法解释标准。药敏试验的药物种类选择依据见表 7。
| 抗菌药物名称 | |
|---|---|
| 必选 | 阿米卡星、阿莫西林-克拉维酸、头孢曲松、头孢西丁、环丙沙星、左氧氟沙星、亚胺培南、利奈唑胺、美罗培南、红霉素、多西环素、复方磺胺甲噁唑、加替沙星、克林霉素 |
| 可选 | 头孢吡肟、头孢噻肟、多西环素 |
注:具体参照《热病:桑福德抗微生物治疗指南》(新译第44版)
(六)星形诺卡菌结果解释与要点提示
(1)诺卡菌在自然界分布广泛,多为腐生寄生菌,是一种机会致病菌,与人类疾病关系最大的是星形诺卡菌和巴西诺卡菌,多为外源性感染。
可引起原发性化脓性肺部感染,出现类似肺结核的症状。肺部病灶可向其他组织器官扩散,引起皮肤、皮下多发性脓肿、软组织感染、胸膜炎等。
巴西诺卡菌可引起足菌肿,表现为腿部或足部皮下脓肿、多发性瘘管等。在患者痰液标本中查找痰标本中硫颗粒,加做改良抗酸染色,可查见诺卡菌。
(2)有些诺卡菌生长缓慢,如在做无菌液体标本培养时,48h未见细菌生长,可延长至72h,若有细菌生长,则补加阳性报告,这样可提高诺卡菌及其他苛养菌的阳性检出率。
(3)诺卡菌抗酸染色,若盐酸乙醇脱色时间>1min显示阴性,缩短脱色时间(<30s)时抗酸染色为弱阳性,因此在做诺卡菌抗酸染色时,要严格控制第二脱色时间(<30s)。
抗酸染色使用不同的脱色剂效果不一样(图 13)。

图 13 血琼脂平板上培养48h星形诺卡菌的菌落涂片做抗酸染色A.用盐酸乙醇脱色≤30s:B 用1%H2SO4脱色至菌膜无色为止
(4)各种诺卡菌在体外药物敏感试验结果见表 8。
| 菌名 | AMC | 阿米卡星 | 头孢曲松 | 环丙沙星 | 克林霉素 | 庆大霉素 | 亚胺培南 | 利奈唑胺 | 四环素 | 米诺环素 | 磺胺甲噁唑 | 妥布霉素 |
|---|---|---|---|---|---|---|---|---|---|---|---|---|
| 脓肿诺卡菌 | S | S | S | S | R | – | R | – | S | – | – | – |
| 巴西诺卡菌 | S | – | – | R | – | – | – | – | S | S | S | – |
| 巴西诺卡菌和少食诺卡菌 | S | S | S | S | R | R | R | S | – | – | – | – |
| N. cyriacigeorgica | R | S | S | S | R | – | – | – | – | – | – | – |
| 皮氏诺卡菌 | – | S | R | S | R | R | S | S | – | – | – | R |
| 星形诺卡菌 | R | S | S | S | – | – | – | – | – | – | – | – |
| 豚鼠耳炎诺卡菌 | R | S | R | S | – | – | S | R | – | – | – | – |
| 假巴西诺卡菌 | R | – | – | S | – | – | – | – | – | – | – | – |
| 南非诺卡菌复合群 | – | – | – | – | – | – | – | – | – | – | – | R |
注:AMC,阿莫西林-克拉维酸。–,没有一致的结果;S,敏感;R,耐药
(5)星形诺卡菌药物治疗选择
星形诺卡菌药物治疗选择见表 9。
| 首选 | 次选 | 其他有效药物 |
|---|---|---|
| TMP-SMX+亚胺培南 | 利奈唑胺 | 阿米卡星+亚胺培南或头孢曲松、头孢曲松 |
注:具体参照《热病:桑福德抗微生物治疗指南》(新译第44版)
二、巴西诺卡菌(N. brasiliensis)
(一)巴西诺卡菌形态与染色
革兰染色阳性或不定,菌体呈分枝丝状,不形成芽胞,无鞭毛(图 14)。

图 14巴西诺卡菌纯培养的镜下形态(革兰染色,18~24h)
(二)巴西诺卡菌培养特性
在血平板琼脂平板上,35℃培养18~24h,菌落呈针尖大小或不易见到(图 15),48h后逐渐增大,有皱褶,呈白色。
图 15巴西诺卡菌在血琼脂平板上的菌落特征(18~24h)
在血琼脂平板上,28℃均可缓慢生长,48h菌落表面有皱褶,呈白色(图 16)。
图 16巴西诺卡菌在血琼脂平板上的菌落特征(48h)
(三)巴西诺卡菌生化反应
触酶试验阳性,主要生化反应见表 10。
| 试验 | 结果 | 试验 | 结果 |
|---|---|---|---|
| 45 ℃生长 | – | 次黄嘌呤 | + |
| 芳基硫酸酯酶 | – | 酪氨酸 | + |
| 硝酸盐 | + | 黄嘌呤 | – |
| 脲酶 | + | 乙酰胺 | – |
| 腺嘌呤 | – | 枸橼酸盐 | + |
| 酪蛋白 | + | 鼠李糖 | – |
| 七叶苷 | + | 山梨醇 | – |
注:+,90%以上菌株阳性;–,90%以上菌株阴性
(四)巴西诺卡菌鉴别要点
1. 本菌特征:革兰阳性,菌体为丝状。酪蛋白、酪氨酸、枸橼酸盐试验阳性。
2. 与星形诺卡菌、豚鼠耳炎诺卡菌鉴别的关键试验见表 11。
| 巴西诺卡菌 | 星形诺卡菌 | 豚鼠耳炎诺卡菌 | |
|---|---|---|---|
| 硝酸盐 | + | + | – |
| 酪蛋白 | + | – | – |
| 七叶苷 | + | – | + |
| 次黄嘌呤 | + | – | + |
| 酪氨酸 | + | – | – |
| 枸橼酸盐 | + | – | – |
注:+,90%以上菌株阳性;–,90%以上菌株阴性
(五)巴西诺卡菌药敏试验的药物种类选择
参见星形诺卡菌章节。
(六)巴西诺卡菌结果解释与要点提示
(1)巴西诺卡菌可通过损伤的皮肤侵犯皮下组织,引起慢性化脓性肉芽肿,临床表现为脓肿及多发性瘘管,称为足菌肿,多见于足和腿部。
(2)巴西诺卡菌药物治疗选择参见星形诺卡菌章节。
三、豚鼠耳炎诺卡菌(N. otitidiscaviarum)
(一)豚鼠耳炎诺卡菌形态与染色
革兰染色阳性或不定,菌体呈多向的分枝丝状,也可见念珠状菌体(图 17),随着培养时间的延长(72h),菌体裂解为球形或杆状(图 18)。

图 17豚鼠耳炎诺卡菌纯培养的镜下形态(革兰染色,18~24h)

图 18豚鼠耳炎诺卡菌纯培养的镜下形态(革兰染色,72h)
(二)豚鼠耳炎诺卡菌培养特性
诺卡菌为严格需氧菌。
在血平板琼脂平板上,35℃培养18~24h(图 19),菌落呈针尖大小或不易见到,48h后逐渐增大(图 20),有皱褶,呈黄色或橘黄色,延长培养72h(图 21)。
在沙氏培养基(SDA)或营养琼脂培养基上,28℃均可缓慢生长。

图 19豚鼠耳炎诺卡菌在血琼脂平板上的菌落特征(18~24h)
图 20豚鼠耳炎诺卡菌在血琼脂平板上的菌落特征(48h)
图 21豚鼠耳炎诺卡菌在血琼脂平板上的菌落特征(72h)
(三)豚鼠耳炎诺卡菌生化反应
触酶试验阳性,主要生化反应见表 12。
| 试验 | 结果 | 试验 | 结果 |
|---|---|---|---|
| 触酶 | + | 肌醇 | + |
| 葡萄糖 | + | 脲酶 | + |
| 侧金盏花醇 | – | 硝酸盐还原 | + |
| 鼠李糖 | – | 七叶苷 | + |
| 山梨醇 | – | 腺嘌呤 | + |
注:+,90%以上菌株阳性;–,90%以上菌株阴性
(四)豚鼠耳炎诺卡菌鉴别要点
1. 本菌特征:革兰阳性,菌体为丝状,分枝角粗长,Y形,分枝串珠样,着色不均一。脲酶阳性,分解葡萄糖,不分解侧金盏花醇,次黄嘌呤阳性。
2. 与星形诺卡菌生化反应鉴别见表 13。
| 菌名 | 腺嘌呤 | 七叶苷 | 次黄嘌呤 | 肌醇 |
|---|---|---|---|---|
| 星形诺卡菌 | – | – | – | – |
| 豚鼠耳炎诺卡菌 | + | + | + | + |
注:+,90%以上菌株阳性;–,90%以上菌株阴性
3. 与星形诺卡菌培养特性鉴别见表 14。
| 特征 | 星形诺卡菌 | 豚鼠耳炎诺卡菌 |
|---|---|---|
| 菌落特点 | 菌落易刮取,生理盐水中易乳化 | 干燥,片状,不易抹开 |
| 菌落颜色 | 白色,一周后变淡黄 | 5日后土黄色 |
| 培养一周菌落形态 | “宝塔糖”“小喷泉”样 | 扁平皱褶,中间凹陷 |
| 咬琼脂现象 | 明显 | 不明显 |
| 泥土味 | 淡淡的 | 浓郁的 |
(五)豚鼠耳炎诺卡菌药敏试验的药物种类选择
参见星形诺卡菌章节。
(六)豚鼠耳炎诺卡菌结果解释与要点提示
豚鼠耳炎诺卡菌较为少见,化脓性肉芽肿是其典型表现。
四、皮氏诺卡菌(N. farcinica)
(一)皮氏诺卡菌形态与染色
革兰染色阳性或不定,菌体呈多向的分枝丝状(图 22A),抗酸染色呈弱阳性(图 22B),腹水标本直接涂片(图 23)。


图 22 皮氏诺卡菌纯培养的镜下形态A.革兰染色.18~24h;B弱抗酸染色,48h

图 23 皮氏诺卡菌在腹水标本涂片中的镜下形态(革兰染色)
(二)皮氏诺卡菌培养特性
在血平板琼脂平板上,35℃培养18~24h(图 24),菌落呈针尖大小或不易见到,48 h后逐渐增大(图 25),72h后有皱褶,呈黄色或橘黄色。
图 24 皮氏诺卡菌在血琼脂平板上的菌落特征(18~24h)
图 25 皮氏诺卡菌在血琼脂平板上的菌落特征(48h)
在沙氏培养基(SDA)上,28℃均可缓慢生长,48h菌落表面有皱褶,呈白色。
(三)皮氏诺卡菌生化反应
触酶试验阳性,主要生化反应见表 15。
| 试验 | 结果 | 试验 | 结果 |
|---|---|---|---|
| 45 ℃生长 | – | 次黄嘌呤 | – |
| 芳基硫酸酯酶 | – | 酪氨酸 | + |
| 硝酸盐 | – | 黄嘌呤 | – |
| 脲酶 | + | 乙酰胺 | + |
| 腺嘌呤 | – | 枸橼酸盐 | – |
| 酪蛋白 | – | 鼠李糖 | + |
| 七叶苷 | – | 山梨醇 | – |
注:+,90%以上菌株阳性;–,90%以上菌株阴性
(四)皮氏诺卡菌鉴别要点
1. 本菌特征:革兰阳性,菌体为丝状,脲酶试验、酪氨酸试验、乙酰胺试验、鼠李糖试验均为阳性。
2. 与其他诺卡菌鉴别见表 16。
| 试验 | 皮氏诺卡菌 | 豚鼠耳炎诺卡菌 | 星形诺卡菌 | 巴西诺卡菌 |
|---|---|---|---|---|
| 45 ℃生长 | – | V | – | – |
| 硝酸盐 | – | – | + | + |
| 酪蛋白 | – | – | – | + |
| 七叶苷 | – | + | – | + |
| 酪氨酸 | + | – | – | + |
| 枸橼酸盐 | – | – | – | + |
| 鼠李糖 | + | – | – | – |
注:+,90%以上菌株阳性;–,90%以上菌株阴性;V,11%~89%菌株阳性
(五)皮氏诺卡菌药敏试验的药物种类选择
参见星形诺卡菌章节。
(六)皮氏诺卡菌结果解释与要点提示
皮氏诺卡菌在自然界分布广泛,多为腐生寄生菌,是一种机会致病菌。
参考文献
周庭银, 章强强 主编. 临床微生物学诊断与图解(第4版)[M]. 上海: 上海科学技术出版社, 2019.
相关产品
HZB353408:星形诺卡菌 | Nocardia asteroides
HZB597380:巴西诺卡氏菌 | Nocardia brasiliensis
HZB920109:豚鼠耳炎诺卡氏菌 | Nocardia otitidiscaviarum
HZB592406:皮氏诺卡菌 | Nocardia farcinica
敬请关注灰藻生物,共筑健康未来!
— 武汉市灰藻生物科技有限公司团队敬上
灰藻生物:我们期待着与客户共同成长,共创生命科学的美好未来!
更新日期:2026-03-12
编制人:木木
审稿人:小藻
